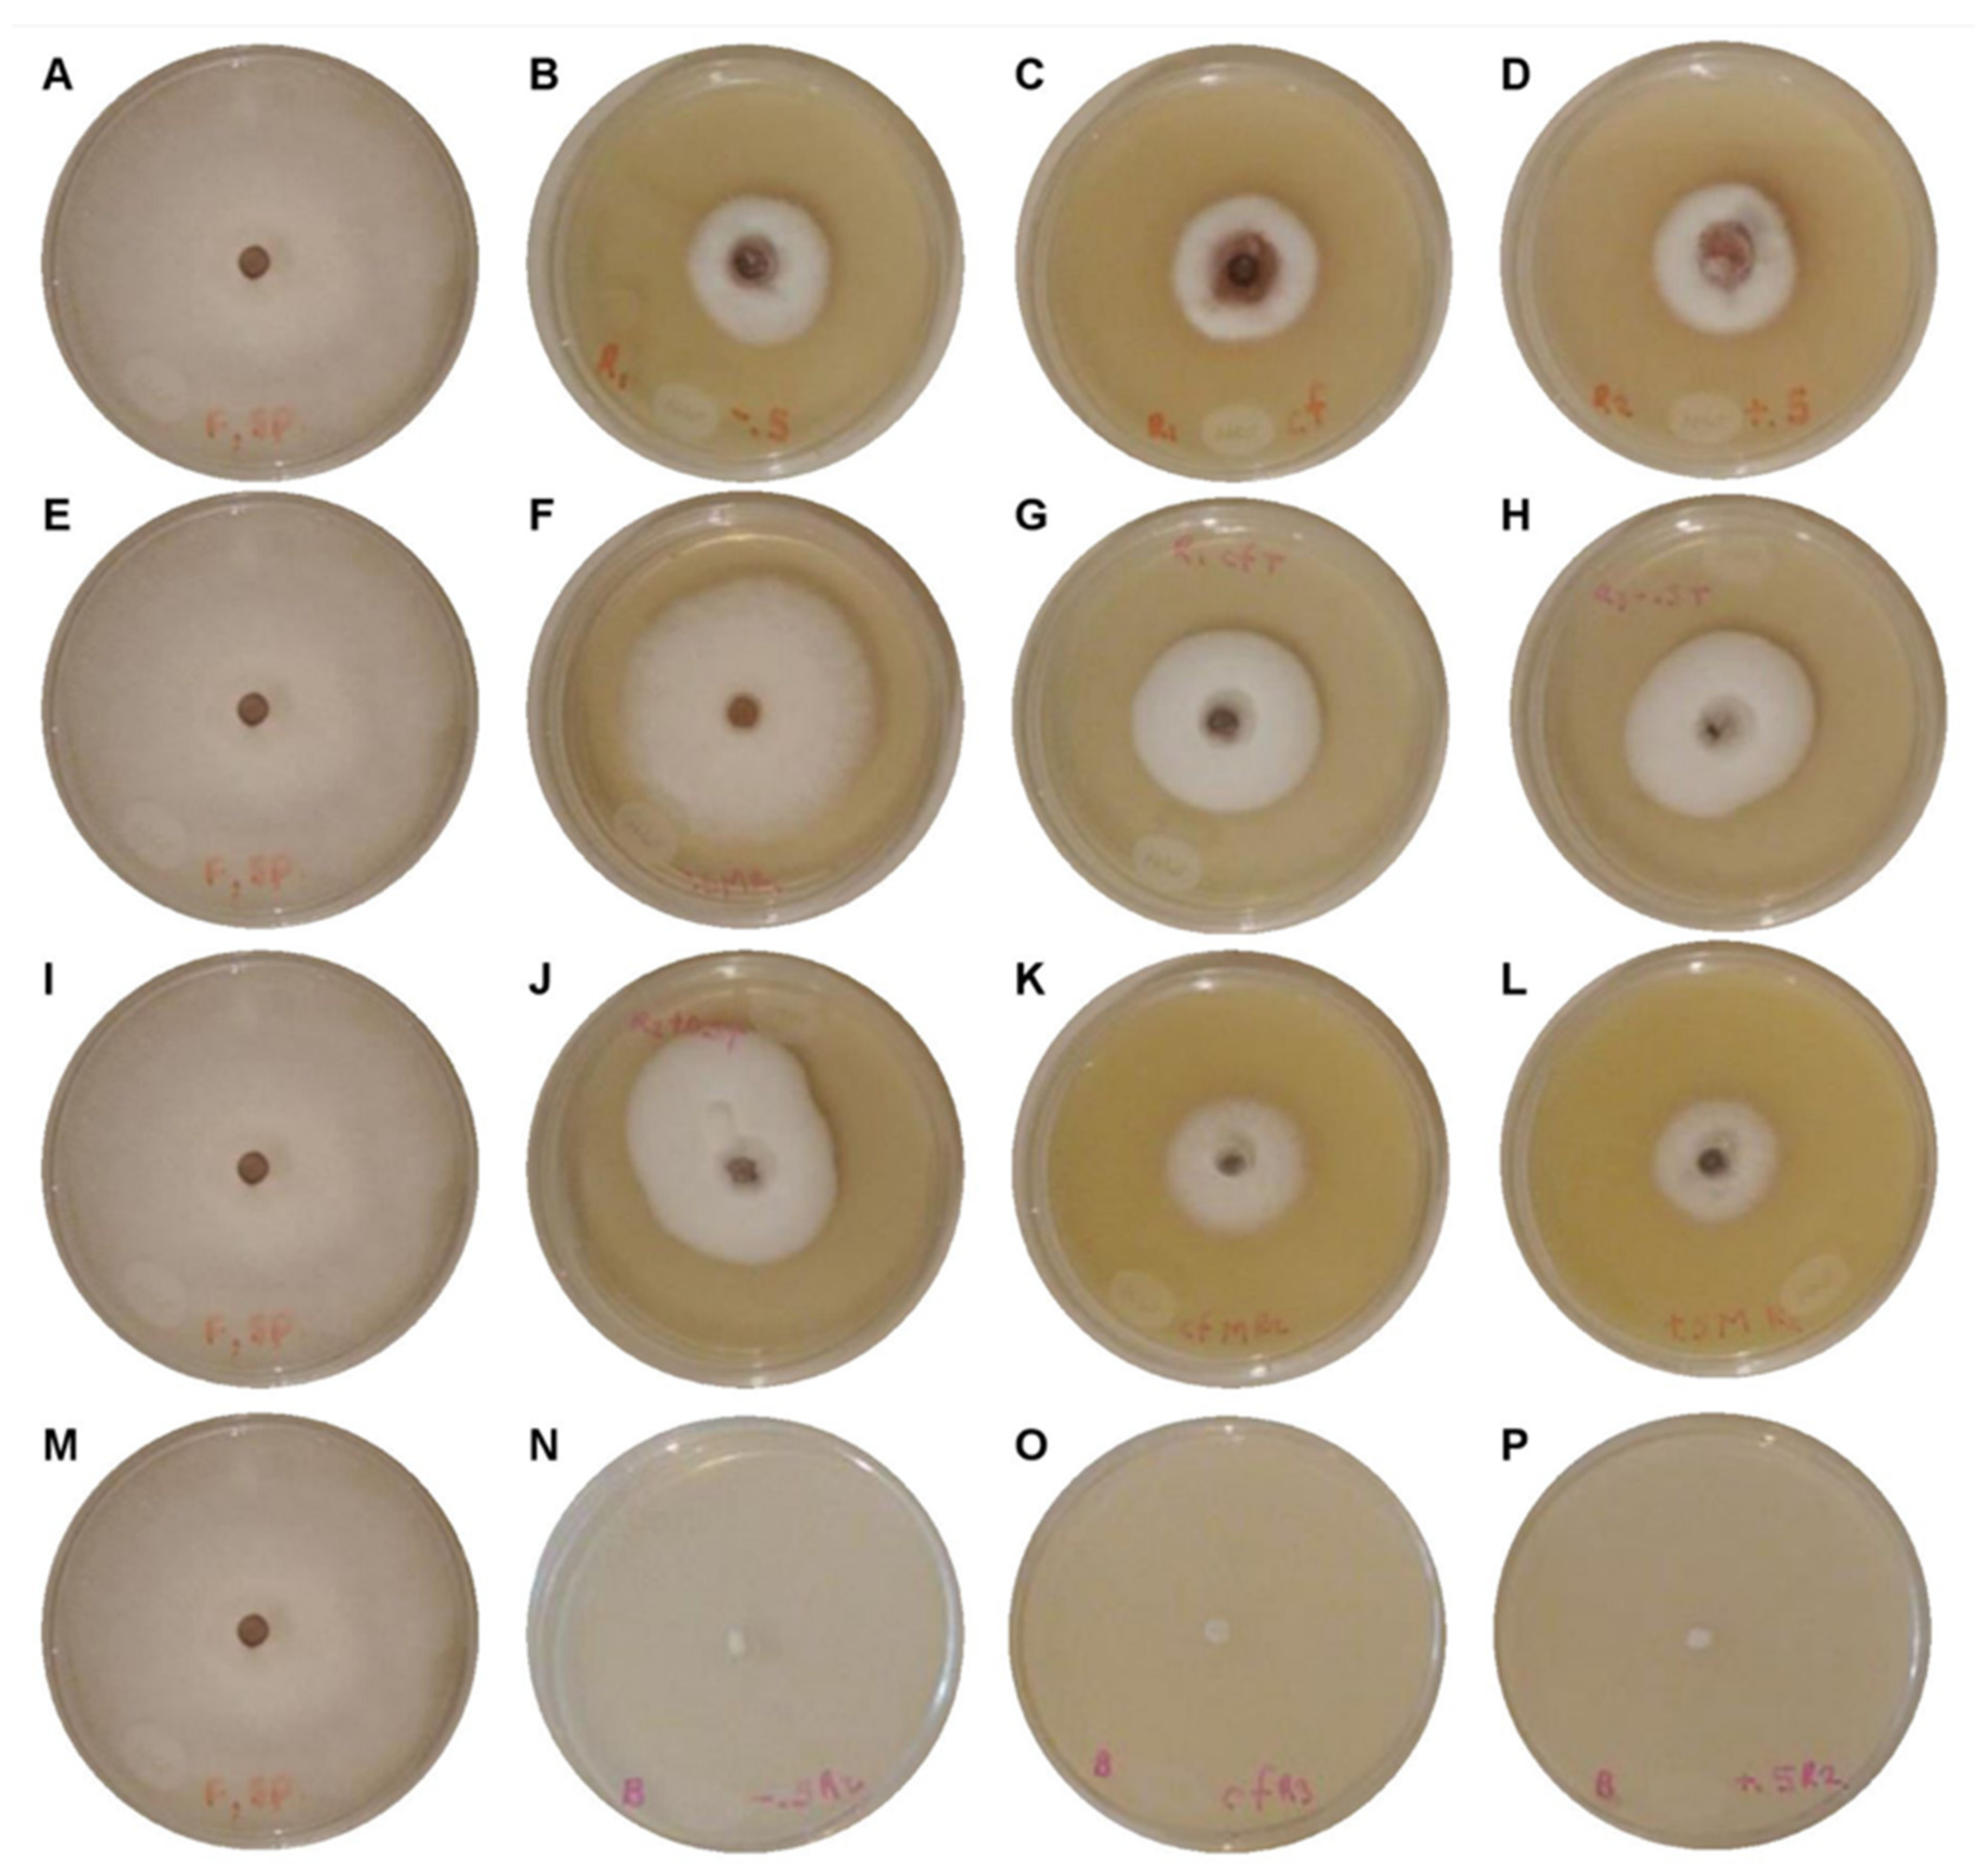
Applsci 12 03213 g004

Efficacy of Four In Vitro Fungicides for Control of Wilting of Strawberry Crops in Puebla-Mexico
Abstract
1. Introduction
2. Materials and Methods
2.1. Isolation Area
2.2. Isolation of F. solani from Plant Tissues
2.3. Morphological Characterization
2.4. DNA Extraction, PCR Amplification, and Sequencing
2.5. Pathogenicity Tests
2.6. In Vitro Sensitivity Bioassay
2.7. Mycelial-Growth Inhibition
- Y = distance
- M = pending
- X = time
- B = the constant factor.
- I% = percent growth reduction in F. solani
- C = colony growth (cm) in the control
- T = colony growth (cm) in the treatment.
2.8. Statistical Analysis
- Iγj = value of response variable of experimental unit associated with the γ-th treatment, and to the j-th repetition
- μ = corresponds to general average of response variable in the experiment
- ti = effect of γ-th treatment
- εγj = error of experimental unit associated with the γ-th treatment
- j-th = repetition
- γ = 1, 2, 3, 4 … 13
- j = 1, 2, 3
- I = variable under study (I%).
3. Results
3.1. Isolation, Characterization, and Identification of Causal Agent of Wilting on Strawberry Crops
3.2. Pathogenicity Tests
3.3. In Vitro Sensitivity Bioassay and Mycelial-Growth Inhibition
4. Discussion
5. Conclusions
Author Contributions
Funding
Institutional Review Board Statement
Informed Consent Statement
Data Availability Statement
Acknowledgments
Conflicts of Interest
References
- Sharma, V.K.; Godara, A.K. Growth responses of strawberry (Fragaria × ananassa duch.) plants grown at different planting density using pvc pipe under protected cultivation. Bangladesh J. Bot. 2019, 48, 1–7. [Google Scholar] [CrossRef]
- Morales-Mora, L.A.; Andrade-Hoyos, P.; Valencia-de Ita, M.; Romero-Arenas, O.; Silva-Rojas, H.V.; Contreras-Paredes, C.A. Caracterización de hongos asociados al cultivo de fresa y efecto antagonista in vitro de Trichoderma harzianum. Rev. Mex. Fitopatol. 2020, 38, 434–449. [Google Scholar]
- Yadav, R.B. Potential benefits of berries and their bioactive compounds as functional food component and immune boosting food. In Immunity Boosting Functional Foods to Combat COVID-19, 1st ed.; Giri, A., Ed.; CRC Press: London, UK, 2021; pp. 75–90. [Google Scholar] [CrossRef]
- U.S. Department of Agriculture (USDA). National Agricultural Statistics Service. Available online: https://downloads.usda.library.cornell.edu/usda-esmis/files/zs25x846c/sf269213r/6t054c23t/ncit0521.pdf (accessed on 21 January 2022).
- Antunes, L.E.C.; Reisser Juniory, C.; Bonow, S. Morango produção aumenta ano a ano. Anuário HF 2021, 1, 87–90. [Google Scholar]
- Organización de las Naciones Unidas para la Alimentación y la Agricultura (FAO). Available online: https://www.fao.org/faostat/es/#data/QCL (accessed on 21 January 2022).
- Servicio de Información Agroalimentaria y Pesquera (SIAP). Available online: https://nube.siap.gob.mx/gobmx_publicaciones_siap/pag/2020/Atlas-Agroalimentario-2020 (accessed on 21 January 2022).
- Ceja-Torres, L.F.; Mora-Aguilera, G.; Téliz, D.; Mora-Aguilera, A.; Sánchez-García, P.; Muñoz-Ruíz, C.; Tlapal-Bolaños, B.; De La Torre-Almaraz, R. Ocurrencia de hongos y etiología de la secadera de la fresa con diferentes sistemas de manejo agronómico. Agrociencia 2008, 42, 451–461. [Google Scholar]
- Martínez, F.; Castillo, S.; Carmona, E.; Avilés, M. Dissemination of Phytophthora cactorum, cause of crown rot in strawberry, in open and closed soilless growing systems and the potential for control using slow sand filtration. Sci. Hortic. 2010, 1254, 756–760. [Google Scholar] [CrossRef]
- Abd-Elgawad, M.M.M.; Elshahawy, I.E.; Abd-El-Kareem, F. Eficacia de la solarización del suelo en la enfermedad de la podredumbre de la raíz negra y especulación sobre su influencia en nematodos y malezas de fresa en Egipto. Bull. Natl. Res. Cent. 2019, 43, 175. [Google Scholar] [CrossRef]
- Bárcenas-Santana, D.; Guillén-Sánchez, D.; Yazmín-Basaldua, C.; Ramos-García, M.L.; Valle-de la Paz, M. Etiology Strawberry dry wilt (Fragaria spp.) in Morelos, Mexico. Rev. Mex. Fitopatol. 2019, 37, 454–463. [Google Scholar] [CrossRef]
- Pastrana, A.M.; Capote, N.; De los Santos, B.; Romero, F.; Basallote-Ureba, M.J. First report of Fusarium solani causing crown and root rot on strawberry crops in southwestern Spain. Plant Dis. 2014, 98, 161. [Google Scholar] [CrossRef]
- De la Lastra, E.; Villarino, M.; Astacio, J.D.; Larena, I.; De Cal, A.; Capote, N. Genetic diversity and vegetative compatibility of Fusarium solani species complex of strawberry in Spain. Phytopathology 2019, 109, 2142–2151. [Google Scholar] [CrossRef]
- Summerell, B.A.; Leslie, J.F. Fifty years of Fusarium: How could nine species have ever been enough? Fungal Divers. 2011, 50, 135–144. [Google Scholar] [CrossRef]
- Chitrampalam, P.; Abraham, N.; Nelson, B.D.A., Jr. Culture-independent PCR-based assay to detect the root rot pathogen Fusarium solani species complex 11 from soybean roots and soil. Plant Dis. 2018, 102, 327–333. [Google Scholar] [CrossRef] [PubMed]
- Villarino, M.; De la Lastra, E.; Basallote-Ureba, M.J.; Capote, N.; Larena, I.; Melgarejo, P.; De Cal, A. Characterization of Fusarium solani populations associated with Spanish strawberry crops. Plant Dis. 2019, 103, 1974–1982. [Google Scholar] [CrossRef] [PubMed]
- Manici, L.M.; Caputo, F.; Baruzzi, G. Additional experiences to elucidate the microbial component of soil suppressiveness towards strawberry black root rot complex. Ann. App. Biol. 2005, 146, 421–431. [Google Scholar] [CrossRef]
- Ayoubi, N.; Soleimani, M.J. Morphological and molecular identification of pathogenic Fusarium spp. on strawberry in Iran. Sydowia 2016, 68, 163–171. [Google Scholar]
- Mehmood, N.; Riaz, A.; Jabeen, N.; Anwaar, S.; Hussain, S.Z.; Abbas, M.F.; Zhang, X.; Rosli, H.; Gleason, M.L. First report of Fusarium solani causing fruit rot of strawberry in Pakistan. Plant Dis. 2017, 101, 1681. [Google Scholar] [CrossRef]
- Nel, B.; Steinberg, C.; Labuschagne, N.; Viljoen, A. Evaluation of fungicides and sterilants for potential application in the management of Fusarium wilt of banana. Crop Prot. 2007, 26, 697–705. [Google Scholar] [CrossRef]
- Tarekegn, G.; Sakhuja, P.K.; Swart, W.J.; Tamado, T. Integrated management of groundnut root rot using seed quality and fungicide seed treatment. Int. J. Pest Manag. 2007, 53, 53–57. [Google Scholar] [CrossRef]
- Madhavi, G.B.; Bhattiprolu, S.L. Evaluation of Fungicides, Soil Amendment Practices and Bioagents against Fusarium solani—Causal Agent of Wilt Disease in Chilli. J. Hortic. Sci. 2011, 6, 141–144. [Google Scholar]
- Bejarano, G.F. (Ed.) Los Plaguicidas Altamente Peligrosos en México; Red de Acción sobre Plaguicidas y Alternativas en México, A.C. (RAPAM): Texcoco, México, 2017; pp. 59–110. [Google Scholar]
- García, H.J.; Leyva, M.J.B.; Martínez, R.I.E.; Hernández, O.M.I.; Aldana, M.M.L.; Rojas, G.A.E.; Betancourt, L.M.; Perez, H.N.E.; Perera, R.J.H. Estado actual de la investigación sobre plaguicidas en México. Rev. Int. De Contam. Ambient. 2018, 34, 29–60. [Google Scholar] [CrossRef]
- Qian, H.; Du, J.; Chi, M.; Sun, X.; Liang, W.; Huang, J.; Li, B. The Y137H mutation in the cytochrome P450 FgCYP51B protein confers reduced sensitivity to tebuconazole in Fusarium graminearum. Pest Manag. Sci. 2018, 74, 1472–1477. [Google Scholar] [CrossRef]
- García, E. Modificaciones al Sistema de Clasificación Climática de Köppen, 5th ed.; Instituto de Geografía, Universidad Autónoma de México: México City, México, 2004; pp. 11–90. [Google Scholar]
- Barnett, H.L.; Hunter, B.B. Illustrated Genera of Imperfect Fungi, 4th ed.; The American Phytopatological Society: St. Paul, MN, USA, 2006; pp. 1–197. [Google Scholar]
- Báez-Vallejo, N.; Camarena-Pozos, D.A.; Monribot-Villanueva, J.L.; Ramírez-Vázquez, M.; Carrión-Villarnovo, G.J.; Guerrero-Analco, J.A.; Partida-Martínez, L.P.; Reverchon, F. Forest tree associated bacteria for potential biological control of Fusarium solani and of Fusarium kuroshium, causal agent of Fusarium dieback. Microbiol. Res. 2020, 235, 126440. [Google Scholar] [CrossRef] [PubMed]
- Fisher, N.L.; Marasas, W.F.O.; Toussoun, T.A. Taxonomic importance of microconidial chains in Fusarium section Liseola and effects of water potential on their formation. Mycología 1983, 74, 693–698. [Google Scholar] [CrossRef]
- Morales-Mora, L.A.; Martínez-Salgado, S.J.; Andrade-Hoyos, P.; Valencia de Ita, M.A.; Silva-Rojas, H.V.; Romero-Arenas, O. First report of leaf spot and anthracnosis caused by Pestalotiopsis sp., on strawberry in Puebla, Mexico. Plant Dis. 2019, 103, 2668. [Google Scholar] [CrossRef]
- Rivera-Jiménez, M.N.; Zavaleta-Mancera, H.A.; Rebollar-Alviter, A.; Aguilar-Rincón, V.H.; García-de-los-Santos, G.; Vaquera- Huerta, H.; Silva-Rojas, H.V. Phylogenetics and histology provide insight into damping-off infections of ‘Poblano’ pepper seedlings caused by Fusarium wilt in greenhouses. Mycol. Prog. 2018, 17, 1237–1249. [Google Scholar] [CrossRef]
- White, T.J.; Bruns, T.; Lee, S.; Taylor, J. Amplification and direct sequencing of fungal ribosomal RNA genes for phylogenetics. In PCR Protocols, A Guide to Methods and Applications; Innis, M.A., Gelfand, D.H., Sninsky, J.J., White, T.J., Eds.; Academic Press: New York, NY, USA, 1990; Volume 18, pp. 315–322. [Google Scholar] [CrossRef]
- Kumar, S.; Stecher, G.; Li, M.; Knyaz, C.; Tamura, K. MEGA X: Molecular evolutionary genetics analysis across computing platforms. Mol. Biol. Evol. 2018, 35, 1547. [Google Scholar] [CrossRef]
- Stecher, G.; Tamura, K.; Kumar, S. Molecular evolutionary genetics analysis (MEGA) for macOS. Mol. Biol. Evol. 2020, 37, 1237–1239. [Google Scholar] [CrossRef]
- Azza, R.E.; Hala, M.I.; Sanaa, A.M. The role of storage on Mancozeb fungicide formulations and their antifungal activity against Fusarium oxysporium and Rhizoctonia solani. Arab. J. Chem. 2021, 14, 103322. [Google Scholar] [CrossRef]
- Ortiz-Martínez, L.E.; Robles-Yerena, L.; Leyva-Mir, S.G.; Camacho-Tapia, M.; Juárez-Rodríguez, L. Fusarium sp., causal agent of vascular wilt in citrus and its sensitivity to fungicides. Rev. Mex. Fitopatol. 2021, 40, 1–17. [Google Scholar] [CrossRef]
- Miranda-Granados, J.; Chacón, C.; Ruiz-Lau, N.; Vargas-Díaz, M.E.; Zepeda, L.G.; Álvarez-Gutiérrez, P.; Meza-Gordillo, R.; Lagunas-Rivera, S. Alternative use of extracts of chipilín leaves (Crotalaria longirostrata Hook. & Arn) as antimicrobial. Sustainability 2018, 10, 883. [Google Scholar] [CrossRef]
- Viñuela, E.; Jacas, J.A.; Marco, V.; Adrón, A.; Badia, F. Los efectos de los plaguicidas sobre los organismos beneficiosos en la agricultura y el grupo de trabajo de la OILB. Plaguicidas y organismos beneficiosos I. Insecticidas y acaricidas. Phytoma 1993, 45, 18–25. [Google Scholar]
- Leslie, J.F.; Summerell, B.A. The Fusarium Laboratory Manual, 1st ed.; Blackwell Publishing Professional: Ames, IA, USA, 2006; pp. 3–278. [Google Scholar]
- Šišić, A.; Baćanović-Šišić, J.; Al-Hatmi, A.M.S.; Karlovsky, P.; Ahmed, S.A.; Maier, W.; de Hoog, G.S.; Finckh, M.R. The forma specialis issue in Fusarium: A case study in Fusarium solani f. sp. pisi. Sci. Rep. 2018, 8, 1252. [Google Scholar] [CrossRef]
- Kurt, Ş.; Uysal, A.; Soylu, E.M.; Kara, M.; Soylu, S. Characterization and pathogenicity of Fusarium solani associated with dry root rot of citrus in the eastern Mediterranean region of Turkey. J. Gen. Plant Pathol. 2020, 86, 326–332. [Google Scholar] [CrossRef]
- Mohamed, A.A.; Behiry, S.I.; Ali, H.M.; EL-Hefny, M.; Salem, M.Z.M.; Ashmawy, N.A. Phytochemical Compounds of Branches from P. halepensis Oily Liquid Extract and S. terebinthifolius Essential Oil and Their Potential Antifungal Activity. Processes 2020, 8, 330. [Google Scholar] [CrossRef]
- Yan, K.; Han, G.; Ren, C.; Zhao, S.; Wu, X.; Bian, T. Fusarium solani infection depressed photosystem performance by inducing foliage wilting in apple seedlings. Front. Plant Sci. 2018, 9, 479. [Google Scholar] [CrossRef] [PubMed]
- Robledo-Buriticá, J.; Ángel-García, C.; Castaño-Zapata, J. Microscopía electrónica de barrido ambiental del proceso de infección de Fusarium solani f. sp. passiflorae en plántulas de maracuyá (Passiflora edulis f. flavicarpa). Rev. Acad. Colomb. Cienc. Exactas 2017, 41, 213–221. [Google Scholar] [CrossRef][Green Version]
- Gu, K.X.; Song, X.S.; Xiao, X.M.; Duan, X.X.; Wang, J.X.; Duan, Y.B.; Hou, Y.P.; Zhou, M.G. A β2-tubulin dsRNA derived from Fusarium asiaticum confers plant resistance to multiple phytopathogens and reduces fungicide resistance. Pestic. Biochem. Physiol. 2019, 153, 36–46. [Google Scholar] [CrossRef]
- Essa, T. Response of some commercial strawberry cultivars to infection by wilt diseases in Egypt and their control with fungicides. Egypt. J. Pathol. 2015, 43, 113–127. [Google Scholar] [CrossRef]
- Kelly, K.; Yagiz, Y.; Li, Z.; Mahnken, G.; Borejsza-Wysocki, W.; Marshall, M.; Sims, C.A.; Peres, N.; do Nascimento, N.M.C. Sensory and Physicochemical Quality, Residual Fungicide Levels and Microbial Load in ‘Florida Radiance’ Strawberries from Different Disease Control Treatments Exposed to Simulated Supply Chain Conditions. Foods 2021, 10, 1442. [Google Scholar] [CrossRef]
- Da Silva, A.N.; de Azevedo, G.B.; Sobrinho, G.G.R.; de Novaes, Q.S. Efecto de los productos químicos y de Trichoderma spp. En control del Fusarium solani de la fruta de pasión. Interciencia 2014, 39, 398–403. [Google Scholar]
- Kumar, G.P.K.; Singh, S.K.; Shikha, S. In vitro efficacy of different fungicides against Fusarium solani isolate causing root rot of papaya (Carica papaya L). Int. J. Chem. Stud. 2020, 8, 221–224. [Google Scholar] [CrossRef]
- FRAC, Fungicide Resistance Action Committee. FRAC Code List 2018: Fungicides Sorted by Mode of Action (Including FRAC Code Numbering). Available online: http://www.phi-base.org/images/fracCodeList.pdf (accessed on 21 January 2022).
- Andrabi, M.; Vaid, A.; Razdan, V.K. Evaluation of different measures to control wilt causing pathogens in chickpea. J. Plant Prot. Res. 2011, 51, 55–59. [Google Scholar] [CrossRef]
- Ibañez, D.; Izquierdo-Bote, D.; González-García, M.B.; Hernández-Santos, D.; Fanjul-Bolado, P. Development of a New Screen-Printed Transducer for the Electrochemical Detection of Thiram. Chemosensors 2021, 9, 303. [Google Scholar] [CrossRef]
- European Parliament. Precision Agriculture: An Opportunity for EU Farmers–Potential Support with the CAP 2014–2020; European Parliament: Brussels, Belgium, 2014; pp. 11–45. [Google Scholar]
- Ayvar-Serna, S.; Díaz-Nájera, J.F.; Vargas-Hernández, M.; Enciso-Maldonado, G.A.; Alvarado-Gómez, O.G.; Ortíz-Martínez, A.I. Actividad antifúngica de pesticidas biológicos, botánicos y químicos sobre el agente causal de la marchitez vascular del jitomate. Rev. Fitotec. Mex. 2021, 44, 617–624. [Google Scholar] [CrossRef]
- Shah, M.U.D.; Ahmad, M.; Sagar, V.; Padder, F.A.; Ahanger, F.A.; Sofi, T.A.; Nabi, A.; Mir, A.A.; Kausar, S. In vitro evaluation of bioagents and fungitoxicants against Fusarium oxysporum and Fusarium solani causing corm rot of saffron (Crocus sativus) in Kashmir, India. Acta Hortic. 2018, 1200, 125–132. [Google Scholar] [CrossRef]
- Monadjemi, S.; El Roz, M.; Richard, C.; Ter Halle, A. Photoreduction of Chlorothalonil fungicide on plant leaf models. Environ. Sci. Technol. 2011, 45, 9582–9589. [Google Scholar] [CrossRef]
- National Center for Biotechnology Information. Available online: https://pubchem.ncbi.nlm.nih.gov/compound/Chlorothalonil (accessed on 12 November 2021).
- Dwivedi, S.K.; Singh, E. In vitro cellulase activity of two wilt causing soil fusaria (Fusarium solani and F. oxysporum f. sp. lycopersici) and efficacy of some pesticides against the said fusaria. J. Appl. Hortic. 2015, 17, 58–65. [Google Scholar]
- Bhaliya, C.M.; Jadeja, K.B. Efficacy of different fungicides against Fusarium solani causing coriander root rot. BioScan 2014, 9, 1225–1227. [Google Scholar]
- Madhusndhan, P.; Gopal, K.; Haritha, V.; Sangale, U.R.; Rao, S.V.R.K. Compatibility of Trichoderma viride with fungicides and efficiency against Fusarium solani. J. Plant Dis. Sci. 2019, 5, 23–26. [Google Scholar]
- Salazar, M.J.A.; Somoza, V.C.E.; Pérez, A.B.; Velásquez, S.M.; Torres, G.G.; Huerta de la Pea, A.; Ortega, M.L.D. Uso y manejo de plaguicidas en diferentes sistemas de producción de fresa en México. PAyDS 2017, 6, 27–42. [Google Scholar] [CrossRef]
- Van Lexmond, M.B.; Bonmatin, J.M.; Goulson, D.; Noome, D.A. Worldwide integrated assessment on systemic pesticides. Environ. Sci. Pollut. Res. 2015, 22, 1–4. [Google Scholar] [CrossRef]
- Wu, T.; Han, B.; Wang, X.; Tong, Y.; Liu, F.; Diao, Q.; Dai, P. Chlorothalonil alters the gut microbiota and reduces the survival of immature honey bees reared in vitro. Pest Manag. Sci. 2022. [Google Scholar] [CrossRef] [PubMed]
- Kara, M.; Öztaş, E.; Boran, T.; Karaman, E.F.; Veskoukis, A.S.; Tsatsakis, A.M. Ameliorative Effects of the Sesquiterpenoid Valerenic Acid on Oxidative Stress Induced in HepG2 Cells after Exposure to the Fungicide Benomyl. Antioxidants 2021, 10, 746. [Google Scholar] [CrossRef] [PubMed]
- Pemán, J.; Canton, E.; Espinel-Ingroff, A. Antifungal drug resistance mechanisms. Expert Rev. Anti Infect. Ther. 2009, 7, 453–460. [Google Scholar] [CrossRef] [PubMed]
- National Center for Biotechnology Information. Available online: https://pubchem.ncbi.nlm.nih.gov/source/hsdb/1655 (accessed on 12 November 2021).
- Asadboland, R.; Eslahi, M.R.; Iranbakhsh, A.R.; Shirzadian, S. Growth inhibition effects of extracts of eight mosses on the phytopathogenic fungus Fusarium solani. J. Crop Prot. 2021, 10, 615–622. [Google Scholar]
- Kordali, S.; Usanmaz, A.; Cakir, A.; Komaki, A.; Ercisli, S. Antifungal and herbicidal effects of fruit essential oils of four Myrtus communis genotypes. Chem. Biodivers. 2016, 13, 77–84. [Google Scholar] [CrossRef]
- Dorugade, S.P.; Walawade, M.N.; Kamble, S.S. Toxicity of fungicides on Fusarium solani causing dry rot of elephant foot yam. Int. J. Adv. Res. 2015, 3, 1501–1504. [Google Scholar]
- Valbuena, D.; Cely-Santos, M.; Obregón, D. Agrochemical pesticide production, trade, and hazard: Narrowing the information gap in Colombia. J. Environ. Manag. 2021, 286, 112141. [Google Scholar] [CrossRef]

| Species (FSSC) | Strain | Isolation Source | Country | No. Access | |
|---|---|---|---|---|---|
| ITS | EF-1α | ||||
| Fusarium solani | MA-FC120 | Strawberry | México | OM473287 | OM616884 |
| Fusarium solani | SVY-402-1 | Pea | EU | KJ437436 | KM044428 |
| Fusarium solani | GuangX17 | Bitter grand | China | KY785014 | KY785024 |
| Fusarium solani | CB24-4 | Ginseng | China | MN637861 | MN650097 |
| Fusarium solani | MJ | Strawberry | Spain | MH300474 | MH300509 |
| Fusarium solani | MY | Strawberry | Spain | MH300482 | MH300517 |
| Fusarium solani | MS | Strawberry | Spain | MH300452 | MH300523 |
| Fusarium solani | MRC 2635 | Wheat | India | MH582403 | MH582423 |
| Fusarium solani | MRC 2805 | Wheat | India | MH582404 | MH582424 |
| Fusarium solani | NRRL 52778 | Chinch | Syria | JF740931 | JF740846 |
| Fusarium oxysporum | Esm3 | Golden berry | Colombia | KJ936621 | JX465113 |
| Fungicide (Commercial Name) | Active Ingredient | Molecular Formula | Concentration (mg L−1) | ||
|---|---|---|---|---|---|
| Low | Recommended | High | |||
| Control | Water | H2O | - | - | - |
| Captan 50® | Captan | C9H8Cl3NO2S | 450 | 900 | 1350 |
| Mancosol 80® | Mancozeb | C4H6MnN2S4 | 600 | 1200 | 1800 |
| Talonil 75® | Chlorothalonil | C8Cl4N2 | 450 | 900 | 1350 |
| Benomyl 50® | Benomyl | C14H18N4O3 | 250 | 500 | 750 |
| Growth Inhibition (%) | Classification |
|---|---|
| <30 | Harmless |
| 30–75 | Slightly toxic |
| 75–90 | Moderately toxic |
| >90 | Toxic |
| Fungicides (Commercial name) | Concentration (mg L−1) | Development Rate * (mm h−1) | Growth Rate * (mm d−1) | I% |
|---|---|---|---|---|
| Control | - | 0.2873 ± 0.0082 d | 6.7104 ± 0.0888 g | 0.00 h |
| Captan 50® | 450 | 0.1557 ± 0.0008 bc | 3.5296 ± 0.0833 d | 47.54 ± 3.12167 e |
| 900 | 0.1426 ± 0.0077 bc | 3.2432 ± 0.1408 d | 51.71 ± 1.31683 d | |
| 1350 | 0.1366 ± 0.0030 bc | 3.1600 ± 0.0806 d | 52.90 ± 1.57778 d | |
| Mancosol 80® | 600 | 0.2632 ± 0.0076 d | 5.9992 ± 0.0847 f | 10.73 ± 4.3486 g |
| 1200 | 0.1658 ± 0.0114 c | 4.4512 ± 0.3004 e | 33.68 ± 5.1496 f | |
| 1800 | 0.1648 ± 0.0011 c | 4.3376 ± 0.0237 e | 35.46 ± 1.64257 f | |
| Talonil 75® | 450 | 0.1427 ± 0.0279 bc | 4.7025 ± 0.7000 e | 29.95 ± 7.43654 f |
| 900 | 0.0961 ± 0.0223 b | 2.4399 ± 0.5936 c | 63.48 ± 6.91699 c | |
| 1350 | 0.0923 ± 0.0244 b | 1.6305 ± 0.5031 b | 75.70 ± 9.65249 b | |
| Benomyl 50® | 250 | 0.00 ± 0.00 a | 0.00 ± 0.00 a | 100.00 a |
| 500 | 0.00 ± 0.00 a | 0.00 ± 0.00 a | 100.00 a | |
| 750 | 0.00 ± 0.00 a | 0.00 ± 0.00 a | 100.00 a |
| Origin | Sum of Squares (Type III) | gL | Mean Square | F | Sig. | |
|---|---|---|---|---|---|---|
| Corrected model | X1 = Treatments | 523.500 a | 26 | 20.135 | 10.738 | <0.001 |
| X2 = Rate of Development | 0.310 b | 26 | 0.012 | 202.898 | <0.001 | |
| X3 = Growth Rate | 330.807 c | 26 | 12.723 | 133.673 | <0.001 | |
| Intersection | X1 | 782.759 | 1 | 782.759 | 417.471 | <0.001 |
| X2 | 0.621 | 1 | 0.621 | 10580.715 | <0.001 | |
| X3 | 477.343 | 1 | 477.343 | 5015.036 | <0.001 | |
| I (%) | X1 | 523.500 | 26 | 20.135 | 10.738 | <0.001 |
| X2 | 0.310 | 26 | 0.012 | 202.898 | <0.001 | |
| X3 | 330.807 | 26 | 12.723 | 133.673 | <0.001 | |
| Error | X1 | 22.500 | 12 | 1.875 | ||
| X2 | 0.001 | 12 | 5.874 × 10−5 | |||
| X3 | 1.142 | 12 | 0.095 | |||
| Total | X1 | 1950.000 | 39 | |||
| X2 | 0.937 | 39 | ||||
| X3 | 782.328 | 39 | ||||
| Total corrected | X1 | 546.000 | 38 | |||
| X2 | 0.311 | 38 | ||||
| X3 | 331.949 | 38 | ||||
Publisher’s Note: MDPI stays neutral with regard to jurisdictional claims in published maps and institutional affiliations. |
© 2022 by the authors. Licensee MDPI, Basel, Switzerland. This article is an open access article distributed under the terms and conditions of the Creative Commons Attribution (CC BY) license (https://creativecommons.org/licenses/by/4.0/).
Share and Cite
Coronel, A.C.; Parraguirre Lezama, C.; Pacheco Hernández, Y.; Santiago Trinidad, O.; Rivera Tapia, A.; Romero-Arenas, O. Efficacy of Four In Vitro Fungicides for Control of Wilting of Strawberry Crops in Puebla-Mexico. Appl. Sci. 2022, 12, 3213. https://doi.org/10.3390/app12073213
Coronel AC, Parraguirre Lezama C, Pacheco Hernández Y, Santiago Trinidad O, Rivera Tapia A, Romero-Arenas O. Efficacy of Four In Vitro Fungicides for Control of Wilting of Strawberry Crops in Puebla-Mexico. Applied Sciences. 2022; 12(7):3213. https://doi.org/10.3390/app12073213
Chicago/Turabian StyleCoronel, Alba Cruz, Conrado Parraguirre Lezama, Yesenia Pacheco Hernández, Olga Santiago Trinidad, Antonio Rivera Tapia, and Omar Romero-Arenas. 2022. "Efficacy of Four In Vitro Fungicides for Control of Wilting of Strawberry Crops in Puebla-Mexico" Applied Sciences 12, no. 7: 3213. https://doi.org/10.3390/app12073213
APA StyleCoronel, A. C., Parraguirre Lezama, C., Pacheco Hernández, Y., Santiago Trinidad, O., Rivera Tapia, A., & Romero-Arenas, O. (2022). Efficacy of Four In Vitro Fungicides for Control of Wilting of Strawberry Crops in Puebla-Mexico. Applied Sciences, 12(7), 3213. https://doi.org/10.3390/app12073213






